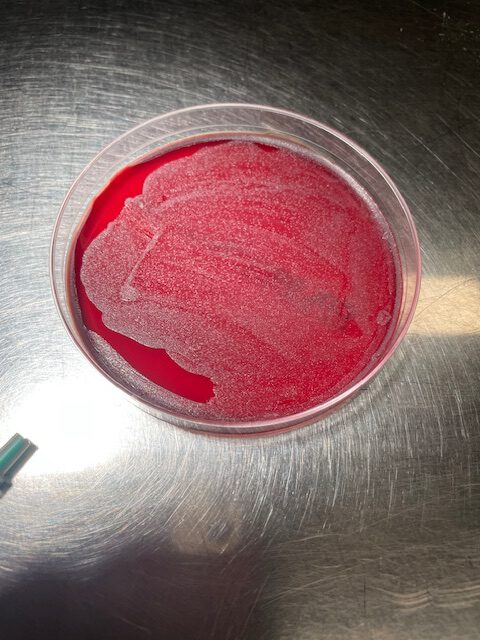

FIP oder Feline Infektiöse Peritonitis ist eine sehr schwerwiegende Erkrankung bei Katzen , die bisher immer tödlich verlief.
Sie wird durch eine Infektion durch Coronaviren hervorgerufen, die üblicherweise unter Katzen sehr verbreitet ist und zu belanglosen Durchfällen führt.
Die Infektion mit Corona ist sehr leicht durch den bisher üblichen Coronatest (ELISA FeCoV) und Titerbestimmung nachzuweisen ist. Dabei entwickeln sowohl Katzen mit negativem Titer ein FIP wie auch Katzen mit extrem hohem Titer kein FIP so dass eine Bestimmung des konventionellen FeCoV-Titers alleine völlig sinnlos ist.
Anhand weiterer Blutuntersuchungen (FIP Screening) kann man aber im Vorfeld schon mal eingrenzen, ob die Katze an FIP erkrankt ist oder nicht. Dazu gehört insbesondere eine Hämatologie, Leberwerte und Elektrophorese mit Bestimmung des Albumin/Globulin Quotienten.
Das körpereigene Immunsystem wird in der Regel auch gut mit der Coronainfektion zurecht und die Katze wieder gesund.
Bei der FIP passiert es aber, dass das Coronavirus mutiert und plötzlich genau die Zellen, die eigentlich die Abwehrfront darstellen, befallen. Diese Mutationen kann man im Labor durch DNA Untersuchungen erfassen. Mutation S1060A und Mutation M1058L sind in Punktaten oder Biopsien durch eine PCR Untersuchung nachweisbar.
Befällt das mutierte Virus die B‑Lymphozyten entwickelt die feuchte Form der FIP befällt es die T‑Lymphozyten entwickelt sich eher die trockene Form. Die genauen Pathomechanismen sind extrem komplex.
Feuchte Form: Erguss in der Pleura (Brust) oder im Bauch. Typischerweise ist das ein gelbes, klares aber eiweissreiches Exsudat. Dieser Erguss muss nun weiter untersucht werden. Erst weisst man durch Messung oder eine sogenannte Rivaltaprobe einen erhöhten Eiweissspiegel (>4%) nach, um es sicher von einem Transsudat (z.B.bei Herzerkrankungen) zu differenzieren. Dann untersucht man es auf die Mutationen mittels PCR. Dazu muss es noch zytologisch unter dem Mikroskop untersucht werden.
Trockene Form: Hier gibt es eine allgemeine Form mit Fieber, Gelbsucht, Nekrosen in Leber und auch Nieren. Als Sonderformen kann die FIP sich als Augenform oder neurologische Form darstellen. Die Diagnose der trockenen Form ist sehr aufwändig.
Therapie: Prinzipiell gibt es einen Durchbruch mit dem Medikament Remdesevir, welches sich auch in der Humanmedizin bei CoVid-Patienten als wirksam erwiesen hat.
Es trägt auch die Bezeichnung GS 441524. Im Internet gibt es zahlreiche Foren, die es aus der chemischen Grundsubstanz angemischt anbieten. Der eigentliche Gehalt an wirksamer Substanz ist dabei aber völlig unterschiedlich. Die daraus hergestellte Injektionslösung ist so sauer, dass sie zu erheblichen Schmerzen und sogar Hautnekrosen führt. Eine Herstellung eines Medikamentes aus einer chemischen Substanz ist aber illegal, und das auch aus gutem Grund.
Als Tierärzte dürfen wir unter der aktuellen Gesetzeslage diese Chemische Substanz nicht verwenden, wir müssen einen anderen Weg gehen. Wir können in Paris über die Pharmacie Delpech https://www.fip.vet eine Formulierung erwerben, die aus dem in der Humanmedizin zugelassenen Medikament VEKLURY (Remdesevir) hergestellt ist.
Diese Medikation ist dann rechtssicher und hat die gesicherte Qualität eines Arzneimittels. Es ist als Paste oder orale Lösung erhältlich. Die Behandlung dauert 84 Tage,
Eine neuere Studie sagt 42 Tage sind auseichend.
Zur Zeit läuft in Frankreich eine großangelegte klinische Studie.
Die Diagnose der FIP ist die eigentliche Challenge: Ich möchte hier ganz explizit auf den Algorithmus verweisen, den man auf den Seiten von Delpech findet. Dabei werden einzelne Fakten bewertet und jeweils mit einer Wahrscheinlichkeitskala von —- bis ++++ versehen. Es gibt 3 Tabellen jeweils für Tiere mit einem Erguss, Tieren mit Augensymptomen, Tieren mit neurologischen Zeichen und Tieren die unspezische Reduzierungen des Allgemeinbefinden zeigen.
Ich habe diese Tabelle als .pdf angefügt, sie ist für die Diagnose extrem hilfreich, leider nur in französischer Sprache

Quelle: Delpech, Paris
Mir persönlich hat sie sehr weitergeholfen, als ich eine 2 jährige Katze untersucht habe, bei der mir bei der Untersuchung auffiel, dass sie etwas angestrengt atmete. Ein Röntgen war schnell gemacht, es lag eindeutig ein Pleuralerguss vor. Das Tier war aber fieberfrei und eigentlich noch bei gutem Allgemeinbefinden.
Danach haben wir den Erguss punktiert und auf der linken Seite ca 80 ml einer gelblichen leicht trüben Flüssigkeit mit Spritze und Dreiwegehahn abgezogen. Danach war auch gleich die Atmung des Tieres besser.
Das Punktat wurde dann weiter untersucht: Rivalta war positiv, also handelte es sich um ein Exsudat, nicht um ein Transsudat. Darüber waren die Herzmarker NtproNB negativ, somit eine kardiale Ursache sehr unwahrscheinlich. Ein Blutbild wurde angefertigt allerdings war es nicht ganz typisch für unsere erste Verdachtsdiagnose FIP,
weil die Katze genau in das Schema passte:
Erguss, Jungtier mit 2 Jahren, männlich, Rassekatze, positiver Rivaltatest.
Das Blutbild zeigt keine Erhöhung der Neutrophilen, keine milde Anämie. Das Gesamteiweiss ist nur sehr moderat erhöht, der Alb/Glb Quotient auch gerade grenzwertig. Es war keine Gelbsucht da und die Leberwerte normal, bzw erniedrigt.
In der PCR wurde zwar ein sehr geringer Gehalt an FeCoV festgestellt, die Mutationen waren aber nicht nachwiesbar.
Unsere Meinung: Das passt NICHT zu einer FIP
wir müssen nochmal nachhaken
Zytologie ist oft ein Gamechanger in der Diagnostik
Daher habe ich die Katze noch einmal punktiert. Man konnte nur noch wenig Flüssigkeit gewinnen. Das Tier erschien auch viel vitaler als bei der Erstuntersuchung.
Nach Aufbereitung der Probe haben wir dann eine Zytologie Ausstrich angefertigt. Hier waren in hoher Zellzahl degenerierte neutrophile Granulozyten und Makrophagen zu erkennen. Dazu im Hintergrund sehr viele Bakterien.
Schließlich kamen wir zur Diagnose “Pyothorax” das Punktat wurde auch noch auf eine Blutagarplatte aufgebracht, die am nächsten Tag voll mit Bakterien bewachsen war.
Die Platte wird eingeschickt und die Kultur für ein Antibiogramm untersucht
Genau hinschauen:
Sieht aus wie FIP und passt ins Schema, ist aber keine FIP.
Wie man im Antibiogramm erkennen kann, ist der Keim gegenüber Amoxicillin/Clavulansäure empfänglich. Dieses ist ein Standard Antibiotikum in der Katzenmedizin und gut verträglich.
Wir machen noch eine Keimdifferenzierung in einem externen Labor um die die Ergebnisse zu validieren. Woher diese eitrige Entzündung gekommen ist, lässt sich nicht mehr nachvollziehen. Oft sind es Fremdkörper, die durch die Speiseröhre stechen und dann weiterwandern, manchmal sind es Bissverletzungen, die selbst abgeheilt sind. Bald wird Frauchen ihren kleinen Liebling wieder gersund in ihre Arme schließen können. Foto folgt